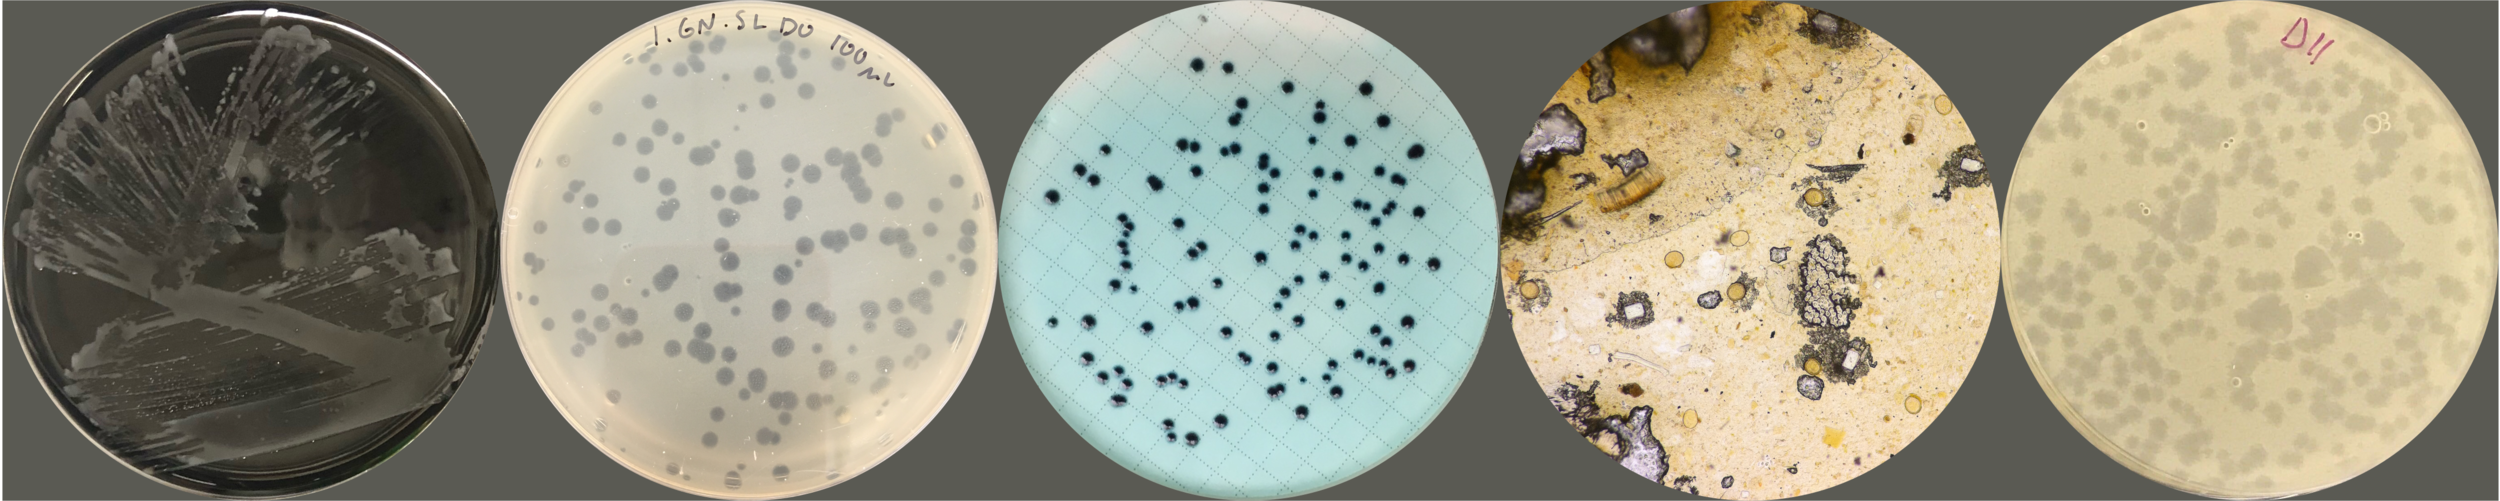

Monitoring disease and managing exposures in our environments.
Environmental microbiology and epidemiology to understand the connections between humans and infectious diseases in our environments.
We use environmental detection of pathogens to understand population health, and to evaluate hazards and risks implement and evaluate interventions that reduce environmental exposure to pathogens.
Our work focuses on communities that are low-resource or facing emergencies to create sustainable and adaptable solutions to understand and manage our relationship to infectious disease in our environment.

-
Monitoring
We identify pathogens in the environment for surveillance of disease burden at a population level and to identify sources of exposure risk for specific pathogens
-
Managing
We evaluate the efficacy of interventions to interrupt transmission of critical pathogens and their effectiveness when used in the real world using a mixed methods approach.

People
Contact us.
marlene.wolfe@emory.edu
Faculty Profile at Emory University
The Wolfe Lab is a part of the Gangarosa Department of Environmental Health in the Rollins School of Public Health at Emory University.
We are recruiting! Please review the information here and reach out to Dr. Wolfe to discuss research and training opportunities.
For media or speaking inquiries, contact Dr. Wolfe at marlene.wolfe@emory.edu